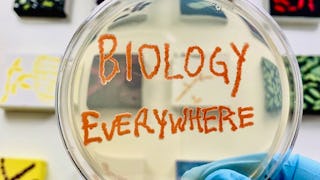

In this course, we will explore the applicability and relationship of biology to the arts, business, and psychology. First, we’ll discuss art as a foundational practice to biology and how biology as a science can explain how we interact with the arts, in particular, our experiences making and listening to music. Next, we will discuss the business of biology and how research is funded and the process of clinical trials and human subjects research. Then we will examine two topics at the interface of psychology and biology: (1) human development from conception to adulthood, and (2) how cognition influences how we make decisions about biological issues and best practices for evaluating biological evidence in light of what we know about how we use evidence to make decisions. We will close with a discussion of education and why evidence-based education is important for promoting overall science literacy.



Specialty Topics: Biology Across Disciplines
This course is part of Biology Everywhere Specialization

Instructor: Melanie Peffer
3,561 already enrolled
Included with 
(32 reviews)
What you'll learn
Describe how biology as a field interfaces with other fields, in particular the arts, business and psychology.
Explain how we use evidence to make decisions and why this is important to consider when promoting science literacy.
Skills you'll gain
Details to know

Add to your LinkedIn profile
See how employees at top companies are mastering in-demand skills

Build your subject-matter expertise
- Learn new concepts from industry experts
- Gain a foundational understanding of a subject or tool
- Develop job-relevant skills with hands-on projects
- Earn a shareable career certificate

There are 5 modules in this course
In this module, we'll explore the intersection of biology with the fine arts.
What's included
4 videos5 readings2 peer reviews1 plugin
In this module, we'll explore how business practices and economics influence biology.
What's included
1 video3 readings1 discussion prompt
This module explores human development, including content typically taught in biology and psychology departments.
What's included
3 videos3 readings1 assignment1 peer review1 discussion prompt1 plugin
How does psychology inform how we engage with biology? This module explores the psychology of decision making, including advice for assessing science information you may encounter over the course of your day.
What's included
2 videos2 readings2 peer reviews
In this final module, we'll explore the future of biology education and how to move forward with the biology everywhere mindset.
What's included
1 video3 readings2 peer reviews
Earn a career certificate
Add this credential to your LinkedIn profile, resume, or CV. Share it on social media and in your performance review.
Instructor

Offered by
Explore more from Basic Science
Status: Free Trial
Status: Free TrialUniversity of Colorado Boulder
 Status: Free Trial
Status: Free TrialUniversity of Colorado Boulder
 Status: Preview
Status: PreviewUniversity of North Texas
 Status: Free Trial
Status: Free TrialRutgers the State University of New Jersey
Why people choose Coursera for their career





Open new doors with Coursera Plus
Unlimited access to 10,000+ world-class courses, hands-on projects, and job-ready certificate programs - all included in your subscription
Advance your career with an online degree
Earn a degree from world-class universities - 100% online
Join over 3,400 global companies that choose Coursera for Business
Upskill your employees to excel in the digital economy
Frequently asked questions
To access the course materials, assignments and to earn a Certificate, you will need to purchase the Certificate experience when you enroll in a course. You can try a Free Trial instead, or apply for Financial Aid. The course may offer 'Full Course, No Certificate' instead. This option lets you see all course materials, submit required assessments, and get a final grade. This also means that you will not be able to purchase a Certificate experience.
When you enroll in the course, you get access to all of the courses in the Specialization, and you earn a certificate when you complete the work. Your electronic Certificate will be added to your Accomplishments page - from there, you can print your Certificate or add it to your LinkedIn profile.
Yes. In select learning programs, you can apply for financial aid or a scholarship if you can’t afford the enrollment fee. If fin aid or scholarship is available for your learning program selection, you’ll find a link to apply on the description page.
More questions
Financial aid available,
¹ Some assignments in this course are AI-graded. For these assignments, your data will be used in accordance with Coursera's Privacy Notice.

